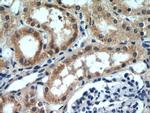
SLIT2 Antibody in Immunohistochemistry (Paraffin) (IHC (P))

Search
Proteintech
SLIT2 Polyclonal Antibody
{{$productOrderCtrl.translations['antibody.pdp.commerceCard.promotion.promotions']}}
{{$productOrderCtrl.translations['antibody.pdp.commerceCard.promotion.viewpromo']}}
{{$productOrderCtrl.translations['antibody.pdp.commerceCard.promotion.promocode']}}: {{promo.promoCode}} {{promo.promoTitle}} {{promo.promoDescription}}. {{$productOrderCtrl.translations['antibody.pdp.commerceCard.promotion.learnmore']}}
产品信息
20217-1-AP
种属反应
已发表种属
宿主/亚型
分类
类型
抗原
偶联物
形式
浓度
规格
纯化类型
保存液
内含物
保存条件
运输条件
产品详细信息
The antibody is specific to SLIT2.
靶标信息
SLIT2 are ligands for Robo receptors and play a vital role for axonal migration/navigation during neural development. A number of cleavage products through alternate splicing are reported in the literature for SLIT2 proteins. The C-terminal cleavage proteins are more diffusible than the larger N-terminal protein that is more tightly cell associated. SLIT2 protein is expressed in tissues such as fetal lung, kidney, and adult spinal cord.
仅用于科研。不用于诊断过程。未经明确授权不得转售。
生物信息学
蛋白别名: downregulated during adipocyte differentiation-1; leucine-rich repeat EGF-like repeat secreted protein; neurogenic extracellular slit protein; secreted ligand for robo receptors; Slit homolog 2 protein; Slit-2; unnamed protein product
基因别名: Drad-1; E030015M03Rik; E130320P19Rik; mKIAA4141; SLIL3; Slit-2; SLIT2
UniProt ID: (Human) O94813, (Mouse) Q9R1B9
Entrez Gene ID: (Human) 9353, (Rat) 360272, (Mouse) 20563